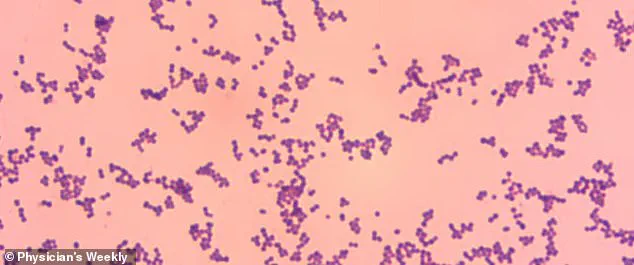
Deadly Threat of Normally Harmless Bacteria Sparks Rising Concerns Over Group G Streptococcus Infections

Deadly Threat of Normally Harmless Bacteria Sparks Rising Concerns Over Group G Streptococcus Infections
A normally harmless bacteria that lurks on the skin of nearly every American left one man fighting for his life after it spread to his bloodstream.
The case, which has sparked renewed concern among medical professionals, highlights the growing threat posed by Group G Streptococcus (GGS), a microorganism that typically coexists peacefully with humans but is now being linked to increasingly severe infections.
This alarming trend has prompted doctors and researchers to reevaluate the role of GGS in public health, raising questions about whether the bacteria itself is evolving or if shifting societal factors—such as aging populations, chronic disease prevalence, and antibiotic resistance—are amplifying its danger.
Group G Streptococcus, or GGS, is typically considered to be safe and a natural part of the human microbiome.
It resides on the skin, in the gut, throat, and female genital tract, where it usually causes no harm.
However, in recent years, doctors have started to sound the alarm over the organism as it is being linked to more severe infections.
These range from life-threatening bloodstream infections to rare but devastating conditions such as meningitis, sepsis, and even blindness.
The shift from benign to dangerous is not fully understood, but experts warn that the implications for public well-being could be profound.
In a new case report from Japan, doctors described how an unidentified 53-year-old man developed meningitis, a dangerous inflammation of the membranes around the brain, heart inflammation, and blindness in his left eye after he was infected with the bacteria.
The individual was hospitalized for 66 days, a grueling ordeal that tested the limits of modern medicine.
Just two days after he was hospitalized, his condition deteriorated rapidly, and he needed to be intubated for five days.
The severity of his symptoms—ranging from high fever and confusion to systemic organ failure—left medical teams scrambling to identify the cause and administer effective treatment.
He was eventually treated with a last-resort antibiotic, reserved for the most severe infections, before being discharged.
Doctors said his case underscores the growing dangers posed by the bacteria.
Physicians at St.

Luke's International Hospital in Tokyo, who treated the man, wrote: 'This case underscores the potential for GGS to cause severe, multisystem invasive disease.
It highlights the importance of early recognition and comprehensive management [of the condition].' Their words serve as a stark reminder that even common bacteria can become deadly under the right circumstances.
GGS normally lives harmlessly on the skin, in the gut, throat, or female genital tract and is normally linked to mild infections such as cellulitis, an infection of the skin, and pharyngitis, a sore throat.
But reports of life-threatening infections have 'substantially increased' in recent years.
Experts are not sure whether this is due to the bacteria becoming more virulent or the declining health of the human population.
Some researchers suggest that changes in the microbiome—driven by factors like overuse of antibiotics, poor nutrition, and chronic stress—may be creating an environment where GGS can thrive and cause harm.
The patient was rushed to the hospital via ambulance, admitted for a presumed bacterial infection in the bloodstream, and given antibiotics.
His initial symptoms were alarming: a fever of 102.2 degrees Fahrenheit, slightly decreased consciousness, and an infection in his left eye that rapidly progressed.
He was also suffering from chills, joint pain, and difficulty moving.
His medical history painted a complex picture of a man who had smoked for two decades and undergone a major surgical procedure 30 years earlier to address a swollen aorta.
The operation had involved replacing the original valve with a prosthetic one to prevent blood backflow, a procedure that likely left his immune system more vulnerable to opportunistic infections.
In the latest case, revealed in the *American Journal of Case Reports*, doctors said the man was admitted to the hospital after suffering from a fever of 102.2 degrees Fahrenheit, slightly decreased consciousness, and an infection in his left eye for two days.
The progression of his condition was swift and severe, with symptoms worsening dramatically within hours of admission.
His case has become a focal point for researchers studying the intersection of microbiology, immunology, and public health.
It has also sparked debates about the need for updated clinical guidelines and increased awareness among healthcare providers about the potential for GGS to cause invasive disease.
As the medical community grapples with this emerging threat, the story of the 53-year-old man serves as a cautionary tale.

It underscores the importance of vigilance, early diagnosis, and aggressive treatment when dealing with infections that may seem innocuous at first.
For the public, it is a reminder that even the most common bacteria can turn deadly—and that the health of individuals is inextricably linked to the health of the broader population.
The challenge now is to understand why GGS is becoming more dangerous and to develop strategies to prevent similar tragedies in the future.
The patient’s journey through the hospital began with a seemingly straightforward diagnosis of a bacterial infection in the bloodstream.
Rushed to the emergency room via ambulance, he was admitted for immediate treatment with standard antibiotics.
However, the medical team quickly realized that this case would not follow the typical trajectory of a simple infection.
Two days into his hospitalization, the man’s condition deteriorated sharply.
His consciousness waned to the point where he appeared listless, able to be roused only by direct verbal stimuli.
This alarming decline prompted an urgent transfer to the intensive care unit, where he was intubated and placed on vancomycin, a powerful antibiotic reserved for the most severe infections.
The use of vancomycin, a drug often considered a last resort, underscored the gravity of the situation and the potential for complications that lay ahead.
The first signs of the infection’s severity became evident in the patient’s left eye.
Scans and clinical assessments revealed a corneal edema, a swelling of the cornea that compromised its clarity, and a ciliary injection, marked by a ring of redness around the eye.
These findings were harbingers of a more insidious complication: endophthalmitis, an infection within the eye that can lead to permanent vision loss.
The infection had not only invaded his ocular tissues but had also spread to the other eye, compounding the challenges faced by the medical team.
The images capturing these abnormalities served as stark visual reminders of the infection’s relentless progression and the urgency of intervention.

As the patient’s condition continued to unfold, further diagnostic tests revealed the full extent of the infection’s reach.
Blood cultures confirmed the presence of GGS (Gordonii, a type of Gram-positive bacteria), while scans from multiple angles—above the head, from the side, and from the back—highlighted a critical finding: an infection in the aortic valve.
This revelation led to a diagnosis of prosthetic valve endocarditis, a life-threatening condition that occurs when the heart’s valves become inflamed due to bacterial infection.
The infection posed a dire risk, as it could damage or block the valve, leading to blood backflow into the heart or impaired pumping function.
Compounding the complexity, the patient also had bacterial meningitis, an infection of the membranes surrounding the brain and spinal cord, further elevating the stakes of his treatment.
The medical team’s response was swift and multifaceted.
The patient was placed on vancomycin again, this time after a brief period of treatment with a milder antibiotic.
His condition showed signs of improvement, with his consciousness returning to normal and his ability to breathe independently restored.
However, the battle was far from over.
On day eight and again on day 24 of his hospitalization, blood tests revealed rising inflammation levels, signaling a resurgence of the infection.
Each time, the administration of vancomycin proved effective, halting the progression and allowing his condition to stabilize.
After a grueling 66-day hospital stay, the patient was finally discharged.
His brain function had returned to normal, but the infection had left a permanent mark: blindness in his left eye, a consequence of the corneal damage caused by the endophthalmitis.
The case raises critical questions about how such infections can develop and spread.
While the exact pathway of the GGS bacteria into the bloodstream remains unclear, the medical team noted the patient’s poor oral hygiene as a potential contributing factor.
This observation highlights the importance of public health initiatives aimed at improving oral care and reducing the risk of bacterial entry into the bloodstream.
Infections originating from the mouth, such as those linked to poor hygiene, can have far-reaching consequences, particularly in individuals with prosthetic valves or other vulnerabilities.
The case underscores the need for both individual responsibility and systemic measures, such as public education campaigns and healthcare policies that promote preventive care.
The medical team’s approach to this case was a testament to the value of clinical vigilance and multidisciplinary collaboration.
Early recognition of the infection’s dual impact on the heart and the eyes was crucial in guiding treatment decisions.
The use of advanced imaging, blood cultures, and timely interventions exemplifies the importance of adhering to evidence-based practices in infectious disease management.
However, this case also serves as a cautionary tale about the limitations of even the most aggressive treatments when faced with rare and complex infections.
The patient’s prolonged hospitalization and the permanent loss of vision in one eye are stark reminders of the risks associated with delayed diagnosis and the challenges of managing multidrug-resistant infections.
From a public health perspective, this case highlights the need for continued investment in infection control protocols, both within healthcare settings and in the broader community.
Hospitals must maintain rigorous standards for sterilization, antibiotic stewardship, and the prevention of healthcare-associated infections.
At the same time, public health campaigns that emphasize the importance of oral hygiene, vaccination, and prompt medical attention for symptoms of infection can play a vital role in preventing similar cases.
The use of vancomycin, while life-saving in this instance, also underscores the growing concern of antibiotic resistance, a challenge that requires coordinated efforts from policymakers, healthcare providers, and the public.
As the patient’s story comes to a close, it leaves behind a legacy of lessons for the medical field and public health systems.
The case is a rare but instructive example of how a single infection can manifest in multiple, life-threatening ways.
It also serves as a call to action for healthcare professionals and policymakers to prioritize prevention, early intervention, and the development of robust regulatory frameworks that protect public well-being.
In an era where infectious diseases continue to evolve and challenge medical science, the importance of vigilance, education, and systemic support cannot be overstated.